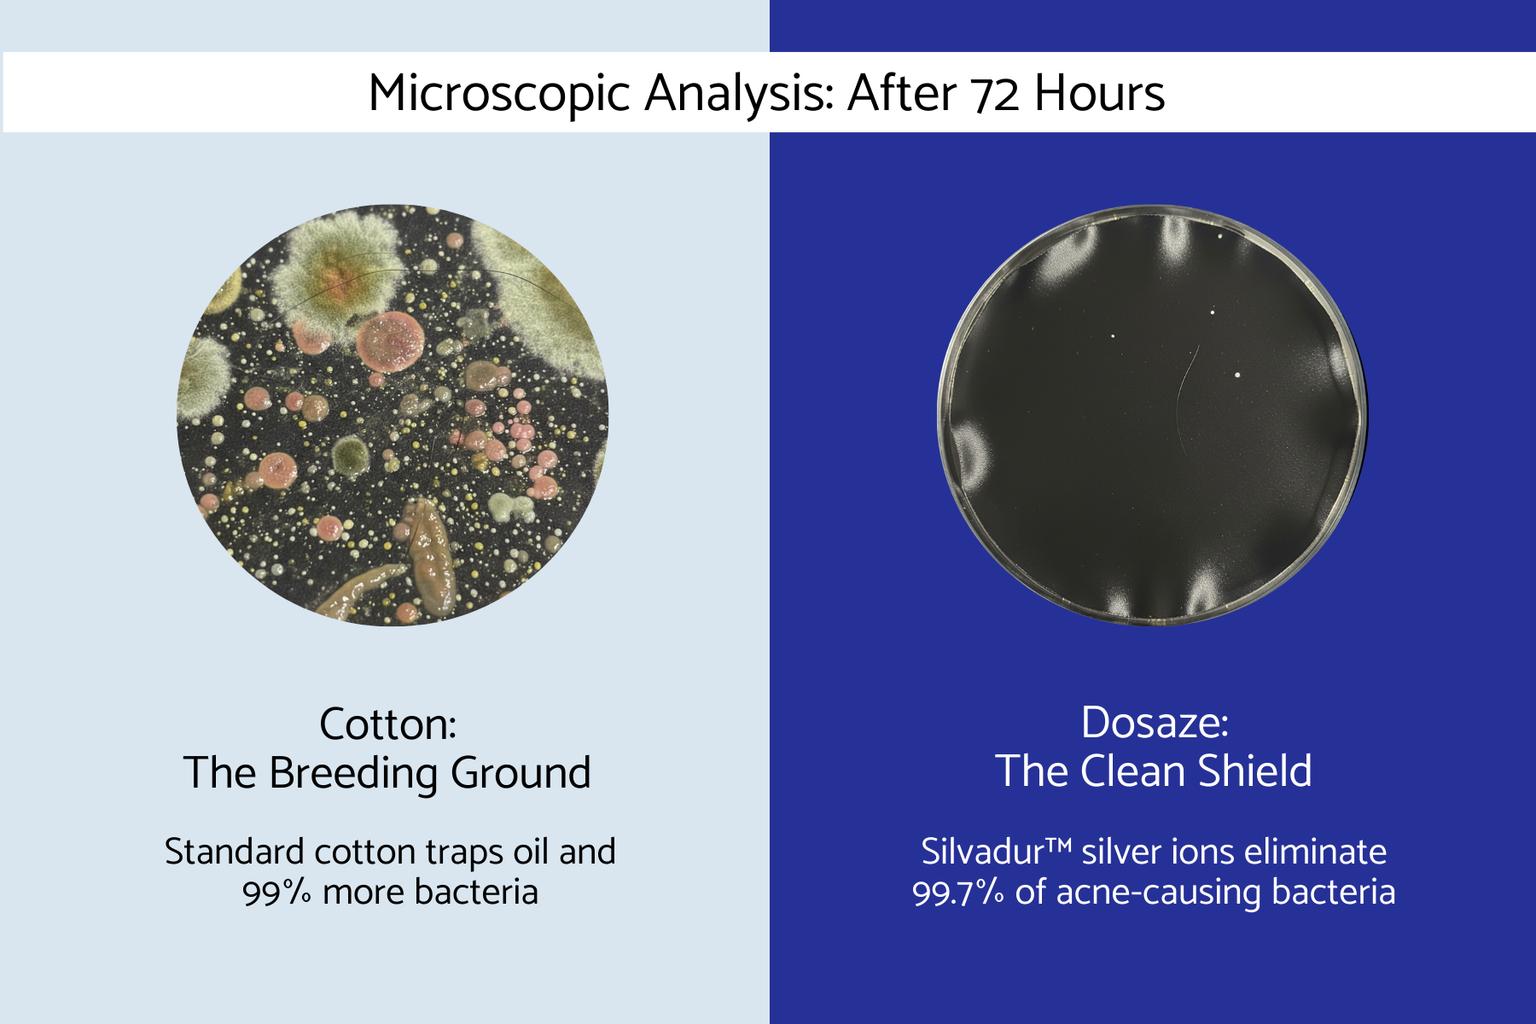

Dosaze Contoured
Orthopedic Pillow
Free Shipping & Returns 🚚 | 60-Night Risk-Free Trial 😴
Free Shipping & Free Returns 🚚 | 60-Night Risk-Free Trial 😴
President's Day Sale! is Here! BOGO on Select Items
President's Day Sale is Here! BOGO on Select Items

Dosaze Contoured
Orthopedic Pillow
"Perfect for curly girls! It's worth every dollar! My curls are noticeably less frizzy in the morning, and I can go three days between washes. It's amazing."
Luz Y.
Your hair and skin will thank you! The difference after just a few days was so noticeable. I love the added antimicrobial feature. I've never seen that in another pillowcase before.
Maria B.
Aside from my skin getting so much better, it's been so comfortable to sleep on especially during the summer. I've never woken up overheated or sweaty.
Lily A.
Very soft to the touch, incredible on hair and skin, and washes easily! I am definitely buying one for the entire family!
Isabel B.
We offer a 60-night risk-free trial on all Dosaze™ Silk Pillowcases.
If you’re not completely satisfied within 60 nights of delivery, you may return your pillowcase for a full refund.
To start a return, email support@dosaze.com with your order number, and our team will guide you through the process.
Simple. Stress-free. Designed with your peace of mind in mind.
Welcome Home.
Back pain doesn’t just come and go. It’s always there.
And you know how debilitating it is.
Back pain can severely impact your quality of sleep, and your quality of life.
Some mattresses promise a solution. Sadly, most mattresses just can’t back it up with features that will actually make a difference.
There’s nothing wrong with these mattresses, they just don’t go the extra mile to actually relieve your back pain — and you know why they don’t really work? Because they don’t target the actual root causes of back pain when you sleep — pressure points, misalignment, and improper support / firmness.
Most mattresses use one layer (or use multiple, thin layers) of foam to relieve pressure points — or, they cheat and use cheaper foam.
In their support layers, they don’t provide enough support for your midsection, so you’ll have a tendency to sink into your mattress.
And finally, they’re usually too firm — did you know that medium firm is the best firmness for back pain relief, according to research? Contrary to popular belief, you don’t need an extra firm mattress to relieve back pain.
Here’s what happens when you send a regular mattress to do the job of a DreamAlign Hybrid Back Relief Mattress=

For a number of reasons, these mattresses simply can’t compete with how much support and relief the DreamAlign mattress can give you.
First, they do not provide adequate support— these mattresses are often made with cheap quality foam or coils that tend to sink when you lie on them. You know, like those cheap innerspring mattresses that you’ve slept on when traveling. You can see how this would cause poor alignment.
Second, most mattresses aren’t actually designed to relieve back pain. You need more than just a “nice” mattress, you need one where every feature was designed to relieve back pain.
Without having all of these elements together, you simply get a mattress that might be nice, but that doesn’t actually relieve back pain and improve your sleep quality.
Enough Already!
Starting from scratch has its advantages. And the need for a three pronged approach to relieving pain was clear to us early.
It’s not just about hype or promises, either.
If it was, we would have used not certified foam, traditional springs, or made our mattress in lower cost markets.
We wanted something not too hard (it would hurt your back), not too soft (it wouldn’t support your body), and definitely not something too hot. It needed to be just right.
We tested ~50 different foam blends and firmness levels with people from all walks of life. Some started off promising, and in the end, all failed. It was so hard we nearly abandoned the project. In the end, we did something experts told us we would never be able to do: we created our own proprietary mattress.
This mattress couldn’t have existed 5 years ago
There is a reason you didn’t see us when you shopped for your last pillow. The technology behind the Dosaze DreamAlign mattress didn’t exist.
We crafted this mattress to solve the support and alignment issues plaguing us and our loved ones — we saw the issues with current pillows and solved them meticulously one by one.
If you’ve made it this far, we want to say thank you. Thank you for allowing us to share our journey to create the perfect mattress with you.There’s a lot of pressure to buy now, act now. Don’t feel rushed. We aren’t going anywhere. And when you’re ready, we look forward to giving you the best quality sleep of your lift. If you have any questions, you can reach our founder, Inno, directly @ inno@dosaze.com and we can answer any questions you have!
And if you try it, and our pillow doesn’t help you, no harm, no foul. You can try our mattress for 365 nights and get a full refund, no questions asked, if you don’t like it.
We look forward to you joining the millions that are sleeping better with Dosaze.
Use this advanced section to add custom HTML, app scripts, or liquid.
Use this advanced section to add custom HTML, app scripts, or liquid.





Benefit for

Benefit for

Benefit for

Benefit for

Benefit for
Benefit for

Benefit for

Benefit for




Dosaze 100% Mulberry Silk pillowcase is not just regular silk. It's 22 Momme, 6A Grade Mulberry silk infused with silver antimicrobial technology.
What it means for you:
Hand wash in cold water and lay flat to dry for best longevity.
You can also machine wash in a laundry bag on a delicate cycle with cold water and gentle detergent. Remove promptly and lay flat to dry.
Avoid bleach and high heat.
Every pillowcase comes with a 60-night satisfaction guarantee.
Try it at home. If it’s not the right fit for you, contact us at support@dosaze.com within 60 days for a full refund.
No pressure. No risk.
For all US, CA, AUS, and UK customers. From our warehouse right to your front door. Free.
Active-duty military, veterans, teachers & healthcare workers save 10% every day.
Subscribe and receive 20% cash back on your first order, plus the occasional sleep tip and deal.
Sleep through the night with this pillow! Awesome!!
I start out sleeping on my back, but usually switch from side-to-side during the night. This pillow accommodates ALL positions for me. Compared to my over-stuffed feather pillow..well, there is no comparison! The Contoured Orthopedic Pillow is my new favorite. There's no changing my mind!
I bought a different pillow that made similar claims and I tossed and turned with it for months. My son gifted me this pillow with the buy one get one offer. The difference between this pillow and what I had is amazing! I have never slept this comfortably. I am a stomach sleeper and usually wake up with sore arms, tight shoulders and an aching neck. I didn't experience any of that with this pillow. I am pain free. And without the constant adjusting my pillow through the night, I feel well rested.
Pleasantly surprised. Most pillows need a few nights to get used to, but not this one. My husband and I have both been sleeping without neck or shoulder pain and we couldn’t be happier.
I have had the deepest sleeps since adjusting to this pillow. It feels weird compared to my down pillow I used to use where I could smush it into ay shape I wanted, but so worth it! I feel way less tension being held in my neck which is the reason I bought it. It is really soft and the perfect firmness of memory foam too which is a plus.
My husband and I were looking for a new pillow and this one was perfect for us both. It’s comfortable and I definitely sleep better at night.
This brand of pillow is FANTASTIC!!! It greatly helps me to alleviate the pain of my back and shoulder. I was struggling with that pain for 10 years, and did research that pillow can alleviate that pain a bit. And I tried several other pillows as well, but the effect didn’t reach my goal. I was hesitant at the beginning because the price of this pillow is really high, and I am still a student. However, I promise this pillow deserves the high price.
This pillow was exactly what I was looking for. Being a side sleeper, I was waking up with a stiff neck and upper back and have a history of ribs coming out of place. This pillow has made a huge difference. My only complaint is that I wish it came in a king size.
I have to support my neck the right way or I get migraines. I've tried several cervical support pillows with varying success and decided to try the Contoured Orthopedic Pillow with the 60 day return if it didn't work.
At first, I loved the pillow, the great feel of the pillow and fabric, but after 2 weeks had 4 days of headaches. I took a 2 week break to try again, but after one night, I woke up with a neck, head, and jaw ache. I made sure i was in the 60 days and packed it up and wrote to customer service that I needed to return it for my refund.
They wrote back with ideas about how to improve my pillow support. Did I think the pillow was too hard, too soft. What could they do to help?
I realized the pillow was too firm.
They said, we'll send you our new Soft Contour Pillow.
I tried it last night, and it was heavenly! I literally felt happy going to sleep with it and woke up after sleeping all night!
Not only that, they said, rather than mailing back the 1st pillow, share the pillow with someone who can enjoy it. Which I have.
These folks make beautiful pillows and they want them to work for us!
Wow, what a beautiful experience!
Thanks so much to the Dosaze team!
I've tried several other ergonomic pillows but Dosaze is the absolute best!. My neck is so much better and my back is improving. Even my chiropractor noticed! You won't be sorry!
I’ve had my Dosaze contour pillow for several months now and will never use another one. I turn over several times a night, and easily find the middle place when I’m on my back and the slightly higher side area for sleeping on my side. I will even take it on vacation despite its size instead of a smaller travel pillow I used in the past. The customer service is great too!
It is not an overstatement to say that this pillow has made a change in my life. I've had to live with problems in the vertebrae at my lower back and neck for years and like most all of the reviewers here, I have tried many types of pillows with varying success. In casual conversation with my daughter in law I complained about how I would wake up during the night from the pain in my neck and how much my lower back ached in the mornings. She and my son had been using the dosaze pillow for a while and spoke so highly of it that on the spot placed an order right then and there. The delivery time was faster than I expected and the tracking updated were very welcome so when I received the pillow I already felt good about it. On the morning after first trying the pillow I woke up and it took me a while to realize I had gotten out of bed faster than I would normally do and that I had not had any neck pain during the night. I felt great but I did not credit that with it having to do with the dosaze pillow. Then after the fourth day of waking up rested and with considerably less pain in my lower back, there was no way to deny that it was the dosaze pillow that was the reason for the relief I was feeling. I try to review products that turn out to be good for me but I normally don't take this much time to review them. This time, though, since this pillow has had such a life changing effect on my wellbeing, I felt I could and should share it with others who are going through what I had been going through in hope that they can find the relief I have found. All the best!
In this hype-ful world, it’s been just wonderful finding the Dosaze orthopedic pillow. It really, truly minimizes my neck pain and stiffness. Also great for shoulder pain. Just this week I had to sleep three nights without it and neck issues came roaring back. What a brilliant product! Thank you.
I am fairly fit and active but I have osteoarthritis throughout my body, including my neck and spine. For years I have been trying various types of pillows (including the P.C. Side Sleeper Pro) but I always wake up with a sore and stiff neck. Well I have been sleeping on your wonderful Dosaze pillow for the past week and this is what I have been searching for! I roll during the night and this pillow is super comfortable on my back or my sides. It really beats all the other "orthopedic" foam pillows I've found and tried.
I have been looking for a pillow for years and have tried many different ones. This one works! I was waking up with severe headaches, shoulder and neck pain, and back pain. That has all gone away while using this pillow. I have finally found the one!!
This pillow is amazing! I have had incredible sleep ever since I received it. I was a bit skeptical until I had my first night. I normally only sleep on goose down pillows, but this pillow supported my neck and gave me a great night sleep. I have not had neck pain since sleeping with this pillow. It works great in any sleeping position.
This pillow works! I have tried at least ten pillows over the years to help my neck pain from injuries while serving in the military and this is the only one that helped with the morning pain. The pillow also helps with a more relaxing sleep feeling much more refreshed in the morning
For years I've invested almost $4,000.00 in pillows, memory foam, cooling memory foam, feathered and all in all what I was left with was absolute pain and Vertigo!....I don't know about you but My vertigo made me dizzy that working on my car or lying down to sleep was agonizing, and sometimes waking up with a hang over headache when I don't drink!....Read the reviews on Dosaze, ordered a pillow and within 4 months, my dizziness was gone, my vertigo %95 gone, my neck is starting to recover from the years of abuse, side sleeping....absolutely fantastic, back sleeping...absolutely awesome...for the money I've spent I definitely refer anyone here....You can't get a better pillow anywhere else. Individual results will very depending on you but for me, it was slow but rewarding....Don't delay, get rid of the neck pain today....what could it hurt to try this pillow out for yourself? Don't expect a miracle overnight but take your time to sleep on it for 90 days/3 months...judge for yourself.
I received my dosage a little over a month ago. After dealing with neck pain for well over a year now, and receiving only very temporary relief from chiropractic adjustments, my neck now feels like it did years ago. I have motion both directions before I had limited when turning to the left. I would recommend this pillow to anyone dealing with neck and shoulder pain.
I was skeptical when I bought this to be honest. I have chronic neck, shoulder and upper back pain, and in the morning they are usually worse. My PT told me to sleep on my back only which is hard to do. I started to research 'pillows for shoulder pain' and one website showed some options and dosaze was one of the top. So I decided to give it a try. And I fell in love with it. I really like the support it provides. I wouldn't say it completely made me pain go away, but I definitely don't feel worse in the morning which is already a life-changer. Only negative feedback: when I bought the pillow I added the pillow case protector too, but when I received it I felt like that was just waste of my money. You can put the pillow in any pillow case (I thought I needed some special pillow case because of the shape). So, I don't suggest you add the protector, just buy the pillow on its own.
I’ve had neck and shoulder pain for years, and I’ve tried lots of things to fix it. Not only have I tried at least 5 other pillows, I’ve also tried chiropractic, massage and physical therapy. This pillow is what’s making a difference. Not to mention I’m sleeping better! I recently went on a trip away from my pillow and the pain started to come back. Couldn’t get home to my new pillow fast enough!! I’ll be traveling with it from now on. Highly recommended.



